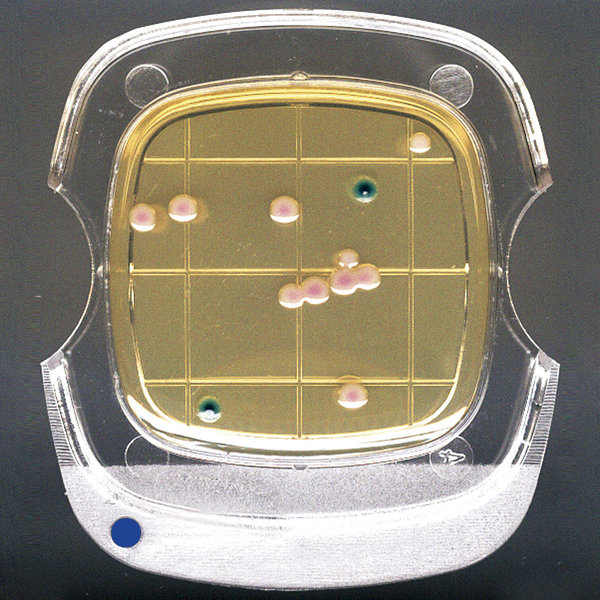
亚速旺ASONE 微生物快速检验测试片 （3M Petrif

相关产品推荐更多 >
万千商家帮你免费找货
0 人在求购买到急需产品
- 详细信息
- 询价记录
- 技术资料
- 库存:
亚速旺ASONE 微生物快速检验测试片 (3M Petrifilm)ペトリフィルムTM培地 MEDIUM
- 英文名:
菌落总数测试片※
- 保质期:
上海辅泽商贸有限公司
- 供应商:
上海辅泽商贸有限公司
- 保存条件:
亚速旺ASONE 微生物快速检验测试片 (3M Petrifilm)ペトリフィルムTM培地 MEDIUM
- 规格:
50片/包
微生物快速检验测试片 (3M Petrifilm)ペトリフィルムTM培地 MEDIUM
检验工序简单,可进行标准化作业。「食品卫生检验指针 微生物篇」收载。
品牌:3M
特点:
● 均匀的干式膜状,做工很好的培养基。
● 无需培养基调节。
● 通过指示剂对菌落进行染色,便于计数。
● 使用后废弃方便。
● 保存及培养时节省空间。
● 还可作为Stamp法使用。
● 与BAM中记载的贝尔德・帕克琼脂培养基+凝固酶试验方法相同的方法。
规格:
● 在全世界60个以上国家使用,获得200种以上的认证・推荐。(AOAC Intl.OMA、AFNOR等等) ※AOAC Intl.OMA(Official Methods of Analysis)认证是符合最高可靠性要求的试验方法,是FDA(美国食品药品监督管理局)使用的检验方法之一。(6420EB除外)

| 编号 | 型号 | 规格 | 数量 | RMB(含税) | 北京库存 | 上海库存 | 日本库存 | 参考货期 | 查询NO. | 选购数量 |
| C6-8641-01 | 6400AC | 菌落总数测试片※ | 50片/包 | 443.00 | 0 | 0 | 0 | 40天左右 | **32 | |
| C6-8641-02 | 6410CC | 大肠菌群数测试片※ | 25片/包 | 310.00 | 5 | 10 | 0 | **32 | ||
| C6-8641-03 | 6404EC | E.coli及大肠菌群/大肠杆菌测试片※ | 25片/包 | 520.00 | 0 | 0 | 0 | 40天左右 | **32 | |
| C6-8641-08 | 6407YM | 霉菌・酵母测试片 | 50片/包 | 670.00 | 0 | 0 | 0 | 40天左右 | **32 | |
| C6-8641-12 | 6420EB | 肠杆菌科测试片 | 25片/包 | 304.00 | 0 | 0 | 0 | 40天左右 | **32 | |
| C6-8641-18 | 6490STX | 金黄色葡萄球菌测试片※ | 25片/包 | 710.00 | 0 | 0 | 0 | 40天左右 | **32 | |
| C6-8641-20 | 6492STX | 金黄色葡萄球菌硧认反应片※ | 20片/包 | 374.00 | 0 | 0 | 0 | 40天左右 | **32 |
※日本在库的情况下,从日本寄送大概需要18天左右
※保存方法:8℃以下
※目录刊载页 : 亚速旺实验用仪器・耗材目录2019号 582页
※目录刊载页 : 亚速旺实验用仪器・耗材目录2017号 302页
培养基 サニ太くんR MEDIUM
品牌:其他
特点:
● 可轻松而准确地进行微生物检测。
● 以食材等样本液检测为首,可通过捣固法・涂抹法・滤膜过滤器法进行检测及落菌数检测。
● 体积小,可长期保存。
● 一般活菌用・大肠菌群用・大肠杆菌・大肠菌群用・真菌用已获得AOAC PTM的I认证。
规格:
● 培养条件:一般活菌用/35℃・48小时、真菌用迅速型/25℃・48~72小时、其他/35℃・24小时





| 编号 | 品名 | 数量 | RMB(含税) | 北京库存 | 上海库存 | 日本库存 | 参考货期 | 查询NO. | 选购数量 |
| C2-5838-21 | 一般活菌用※1 | 25只/袋 | 220.00 | 0 | 0 | 0 | 10天左右 | **32 | |
| C2-5838-22 | 大肠菌群用※ | 25只/袋 | 250.00 | 0 | 0 | 0 | 10天左右 | **32 | |
| C2-5838-34 | 金黄色葡萄球菌用 | 25只/袋 | 510.00 | 0 | 0 | 0 | 10天左右 | **32 | |
| C2-5838-27 | 大肠杆菌・大肠菌群用※1 | 25只/袋 | 510.00 | 0 | 0 | 0 | 10天左右 | **32 | |
| C2-5838-28 | 酵素基质沙门氏菌 | 25只/袋 | 510.00 | 0 | 0 | 0 | 10天左右 | **32 | |
| C2-5838-33 | 真菌用迅速型 | 25只/袋 | 280.00 | 0 | 0 | 0 | 10天左右 | **32 | |
| C2-5838-01 | 一般活菌用#※1# | 25只/袋 | 代替品C2-5838-21 | 0 | 0 | 0 | 另询 | - | |
| C2-5838-02 | 大肠菌群用#※# | 25只/袋 | 代替品c2-5838-22 | 0 | 0 | 0 | 另询 | - | |
| C2-5838-07 | 大肠杆菌・大肠菌群用#※1# | 25只/袋 | 代替品C2-5838-27 | 0 | 0 | 0 | 另询 | - | |
| C2-5838-08 | 酵素基质沙门氏菌 | 25只/袋 | 代替品C2-5838-28 | 0 | 0 | 0 | 另询 | - | |
| C2-5838-13 | 真菌用迅速型 | 25只/袋 | 代替品C2-5838-33 | 0 | 0 | 0 | 另询 | - | |
| C2-5838-14 | 金黄色葡萄球菌用 | 25只/袋 | 代替品C2-5838-34 | 0 | 0 | 0 | 另询 | - |
※日本在库的情况下,从日本寄送大概需要18天左右
※1 「食品卫生检查指针 微生物篇2015」收载产品※保存方法:15℃以下(冷暗处)
※目录刊载页 : 亚速旺实验用仪器・耗材目录2019号 583页
接触性琼脂培养基 生培地 MEDIUM
品牌:ELMEX
特点:
● 广泛适用于环境卫生,工器具,空气尘埃及手的细菌检查
● 开封后直接使用,无需配置培养基,省时、省力
● 培养基面积为10cm2,并分10小格,计数方便
● 本产品应避光常温保存
● 有效期6个月
● 容器内有水滴附着时请轻轻甩掉水滴后使用

| 编号 | 型号 | 规格 | 包装 | 培养时间 | RMB(含税) | 北京库存 | 上海库存 | 日本库存 | 参考货期 | 查询NO. | 选购数量 |
| CC-4305-01 | AS-001 | 细菌总数测定 | 48个/盒 | 24小时 | 360.00 | 0 | 0 | 0 | 30天左右 | **32 | |
| CC-4305-02 | AS-002 | 大肠菌群・E.coli测定 | 48个/盒 | 24小时 | 360.00 | 0 | 0 | 0 | 30天左右 | **32 | |
| CC-4305-03 | AS-003 | 金黄色葡萄球菌测定 | 48个/盒 | 24小时 | 360.00 | 0 | 0 | 0 | 30天左右 | **32 | |
| CC-4305-04 | AS-004 | 酵母菌・霉菌测定 | 48个/盒 | 5~7天 | 360.00 | 0 | 0 | 0 | 30天左右 | **32 |
※日本在库的情况下,从日本寄送大概需要18天左右
※目录刊载页 : 亚速旺实验用仪器・耗材目录2019号 583页
※目录刊载页 : 亚速旺实验用仪器・耗材目录2017号 303页
培养基 (干粉)粉末培地 MEDIUM
品牌:NISSUI/日水

| 编号 | 型号 | 容量 | RMB(含税) | 北京库存 | 上海库存 | 日本库存 | 参考货期 | 查询NO. | 选购数量 |
| CC-4495-01 | TCBS琼脂 | 250g/瓶 | 150.00 | 0 | 0 | 0 | 另询 | **32 | |
| CC-4495-02 | PCA琼脂 | 250g/瓶 | 160.00 | 0 | 0 | 0 | 另询 | **32 | |
| CC-4495-03 | DC琼脂 | 250g/瓶 | 190.00 | 0 | 0 | 0 | 另询 | **32 | |
| CC-4495-04 | 麦凯康琼脂 | 250g/瓶 | 164.00 | 0 | 0 | 0 | 另询 | **32 | |
| CC-4495-05 | EMB琼脂 | 250g/瓶 | 140.00 | 0 | 0 | 0 | 另询 | **32 | |
| CC-4495-06 | EC肉汤 | 250g/瓶 | 140.00 | 0 | 0 | 0 | 另询 | **32 | |
| CC-4495-07 | SCD琼脂(TSA) | 250g/瓶 | 160.00 | 0 | 0 | 0 | 另询 | **32 | |
| CC-4495-08 | R2A琼脂 | 250g/瓶 | 244.00 | 0 | 0 | 0 | 另询 | **32 | |
| CC-4495-09 | TSI琼脂 | 250g/瓶 | 110.00 | 0 | 0 | 0 | 另询 | **32 | |
| CC-4495-10 | 马铃薯葡萄糖琼脂培养基 | 250g/瓶 | 150.00 | 0 | 0 | 0 | 另询 | **32 | |
| CC-4495-11 | NGKG琼脂100个 | 250g/瓶 | 235.00 | 0 | 0 | 0 | 另询 | **32 | |
| CC-4495-12 | 营养琼脂(NA) | 250g/瓶 | 130.00 | 0 | 0 | 0 | 另询 | **32 | |
| CC-4495-13 | 卵磷脂-吐温80营养琼脂培养基基础 | 250g/瓶 | 165.00 | 0 | 0 | 0 | 另询 | **32 | |
| CC-4495-14 | Baird-Parker琼脂基础 | 250g/瓶 | 275.00 | 0 | 0 | 0 | 另询 | **32 | |
| CC-4495-15 | 硫乙醇酸盐液体培养基 | 250g/瓶 | 180.00 | 0 | 0 | 0 | 另询 | **32 | |
| CC-4495-16 | 玫瑰红钠琼脂培养基 | 250g/瓶 | 150.00 | 0 | 0 | 0 | 另询 | **32 | |
| CC-4495-17 | 0.5%葡萄糖肉汤培养基 | 250g/瓶 | 110.00 | 0 | 0 | 0 | 另询 | **32 | |
| CC-4495-18 | 大豆酪蛋白琼脂培养基(TSA) | 250g/瓶 | 220.00 | 0 | 0 | 0 | 另询 | **32 | |
| CC-4495-19 | 0.9%无菌氯化钠溶液 | 250g/瓶 | 50.00 | 0 | 0 | 0 | 另询 | **32 | |
| CC-4495-20 | 甘露醇氯化钠琼脂培养基 | 250g/瓶 | 145.00 | 0 | 0 | 0 | 另询 | **32 | |
| CC-5166-01 | CP马铃薯葡萄糖琼脂(PDA) | 250g/瓶 | 145.00 | 0 | 0 | 0 | 2天左右 | **32 | |
| CC-5166-02 | 甘露醇氯化钠卵黄琼脂 | 250g/瓶 | 代替品:停止销售 | 0 | 0 | 0 | 另询 | - | |
| CC-5166-03 | skirrow血琼脂 | 250g/瓶 | 145.00 | 0 | 0 | 0 | 2天左右 | **32 |
※日本在库的情况下,从日本寄送大概需要18天左右
※目录刊载页 : 亚速旺实验用仪器・耗材目录2019号 583页
※目录刊载页 : 亚速旺实验用仪器・耗材目录2017号 303页
培养容器 角型ジャー RECTANGULAR JAR
品牌:MITSUBISHI/三菱
规格:
● 材质:主体・盖子/PC(聚碳酸酯)、卡具/POM(聚缩醛)
● 耐热温度:主体・盖子/-50~140℃、卡具/-30~140℃、培养袋/80℃
● 尺寸:A-111・D-111/W160×L225×H30mm、D-110/W160×L225×H110mm D-112/W245×L310×H115mm、 D-65/W155×L300mm、D-98/W220×L320mm



| 编号 | 型号 | 容量 | 名称 | 最多收存培养皿数 | 数量 | RMB(含税) | 北京库存 | 上海库存 | 日本库存 | 参考货期 | 查询NO. | 选购数量 |
| 6-8668-01 | A-111 | 500ml | 薄型 | 2个 | 1箱(2个) | 1,270.00 | 0 | 0 | 0 | 20天左右 | **22 | |
| CC-5558-01 | D-111 | 500ml | 薄型 | 2个 | 1箱(1个) | 610.00 | 0 | 0 | 0 | 5天左右 | **32 | |
| CC-5558-02 | D-110 | 2.5l | 标准 | 12个 | 1箱(1个) | 700.00 | 0 | 0 | 0 | 5天左右 | **32 | |
| CC-5558-03 | D-112 | 7.0l | 大型 | 42个 | 1箱(1个) | 1,070.00 | 0 | 0 | 0 | 5天左右 | **32 | |
| 81-0391-06 | D-65 | - | W夹小袋 | 2~4个 | 10只 | 137.00 | 0 | 2 | 0 | **32 | ||
| 81-0391-07 | D-98 | - | 自立袋 | 10~14个 | 10只 | 315.00 | 3 | 0 | 0 | **32 | ||
| 6-8668-02 | A-110 | 2.5l | 标准 | 12个皿 | 1箱(1个) | 790.00 | 1 | 24 | 8 | **22 | ||
| 6-8668-03 | A-112 | 7l | 大型 | 42个皿 | 1箱(1个) | 1,110.00 | 0 | 0 | 18 | **22 |
※日本在库的情况下,从日本寄送大概需要18天左右
※收存培养皿数为使用φ90×16mm培养皿时的数值。※不可用于高压灭菌。
※目录刊载页 : 亚速旺实验用仪器・耗材目录2019号 586页
※目录刊载页 : 亚速旺实验用仪器・耗材目录2017号 304页
密封夹具 密閉クリップ CLIP
品牌:MITSUBISHI/三菱
规格:
● 材质:PVC(聚氟乙烯树脂)
● 耐热温度:45℃

| 编号 | 型号 | 尺寸(mm) | 数量 | RMB(含税) | 北京库存 | 上海库存 | 日本库存 | 参考货期 | 查询NO. | 选购数量 |
| 6-8670-02 | A-74(小袋用袋A-92用) | 240 | 1袋(10支) | 284.00 | 0 | 0 | 8 | **22 | ||
| 6-8670-03 | A-172(小袋用袋A-92用) | 240 | 1袋(10支) | 代替品:停产 | 0 | 0 | 0 | 另询 | - |
※日本在库的情况下,从日本寄送大概需要18天左右
※1 必须与培养皿架一起使用。※2 Pouch培养袋中,必须同时放入两个培养皿。 即使只做一个培养,也请放入空另一个培养皿
※目录刊载页 : 亚速旺实验用仪器・耗材目录2019号 586页
※目录刊载页 : 亚速旺实验用仪器・耗材目录2017号 304页
相关推荐
快速取样套装 拭き取り検査キット CRITICAL TESTER
品牌:ELMEX
特点:
● 无需移液管就可直接把样品加样到培养皿和简易培养基上
● 降低检查成本,排除被额外检查器具再次污染的危险
● 断缩了检查时间,排除被额外检查器具再次污染的危险
● 擦拭用的拭子和灭菌稀释液合为一体的密封设计
● 瓶体设有分装功能
规格:
● 灭菌:γ射线灭菌
● 包装数量:400支(10支×10盒×4薄膜包装)
● 材质:瓶盖/聚丙烯、瓶体/聚乙烯、棉棒/聚丙烯、棉球/人造丝

| 编号 | 型番 | 内溶液 | 长度(mm) | RMB(含税) | 北京库存 | 上海库存 | 日本库存 | 参考货期 | 查询NO. | 选购数量 |
| CC-4509-01 | ST-25PBS | 磷酸盐缓冲溶液10ml | 90 | 3,180.00 | 3 | 3 | 0 | **31 | ||
| CC-4509-02 | ST-25BPW | 缓冲蛋白胨水10ml | 90 | 3,280.00 | 0 | 0 | 0 | 另询 | **31 | |
| CC-4509-03 | ST-26PBS | 磷酸盐缓冲溶液10ml | 155 | 3,280.00 | 0 | 0 | 0 | 另询 | **31 | |
| CC-4509-04 | ST-26BPW | 缓冲蛋白胨水10ml | 155 | 3,380.00 | 0 | 0 | 0 | 另询 | **31 |
※日本在库的情况下,从日本寄送大概需要18天左右
※目录刊载页 : 亚速旺实验用仪器・耗材目录2019号 586页
※目录刊载页 : 亚速旺实验用仪器・耗材目录2017号 306页
菌落计数取样条 ウォーターサンプラー WATER SAMPLER
品牌:Merck
特点:
● 使用滤膜过滤器的活菌数检测简易套件。
● 尽管是简易法,相对于以往的标准法仍具有较高的相关性。
● 塑料容器中装入了已灭菌的0.45um孔径滤膜过滤器及和各种粉末培养基,因此不用担心操作过程中可能出现的污染。
● 使用固体样本时,将悬浊了固体样品的灭菌水的上清液作为样品。
规格:
● 过滤器材质:混合纤维素酯(含格子)
● 器件材质:搅棒/PE、容器/SAN

| 编号 | 型号 | 规格 | 数量 | RMB(含税) | 北京库存 | 上海库存 | 日本库存 | 参考货期 | 查询NO. | 选购数量 |
| C1-4444-01 | MHPC10025 | HPC总活菌用取样器(红色) | 1包(25个) | 2,016.00 | 0 | 4 | 0 | **31 | ||
| C61-0201-32 | MC0010025 | 大肠菌群用取样器(蓝色) | 1包(25个) | 2,110.00 | 0 | 0 | 0 | 15天左右 | **31 | |
| C61-0201-33 | MY0010025 | 酵母和霉菌用取样器(黄色) | 1包(25个) | 2,130.00 | 0 | 0 | 0 | 15天左右 | **31 |
※日本在库的情况下,从日本寄送大概需要18天左右
※目录刊载页 : 亚速旺实验用仪器・耗材目录2019号 586页
风险提示:丁香通仅作为第三方平台,为商家信息发布提供平台空间。用户咨询产品时请注意保护个人信息及财产安全,合理判断,谨慎选购商品,商家和用户对交易行为负责。对于医疗器械类产品,请先查证核实企业经营资质和医疗器械产品注册证情况。
- 作者
- 内容
- 询问日期
亚速旺ASONE 微生物快速检验测试片 (3M Petrifilm)ペトリフィルムTM培地 MEDIUM
¥443











